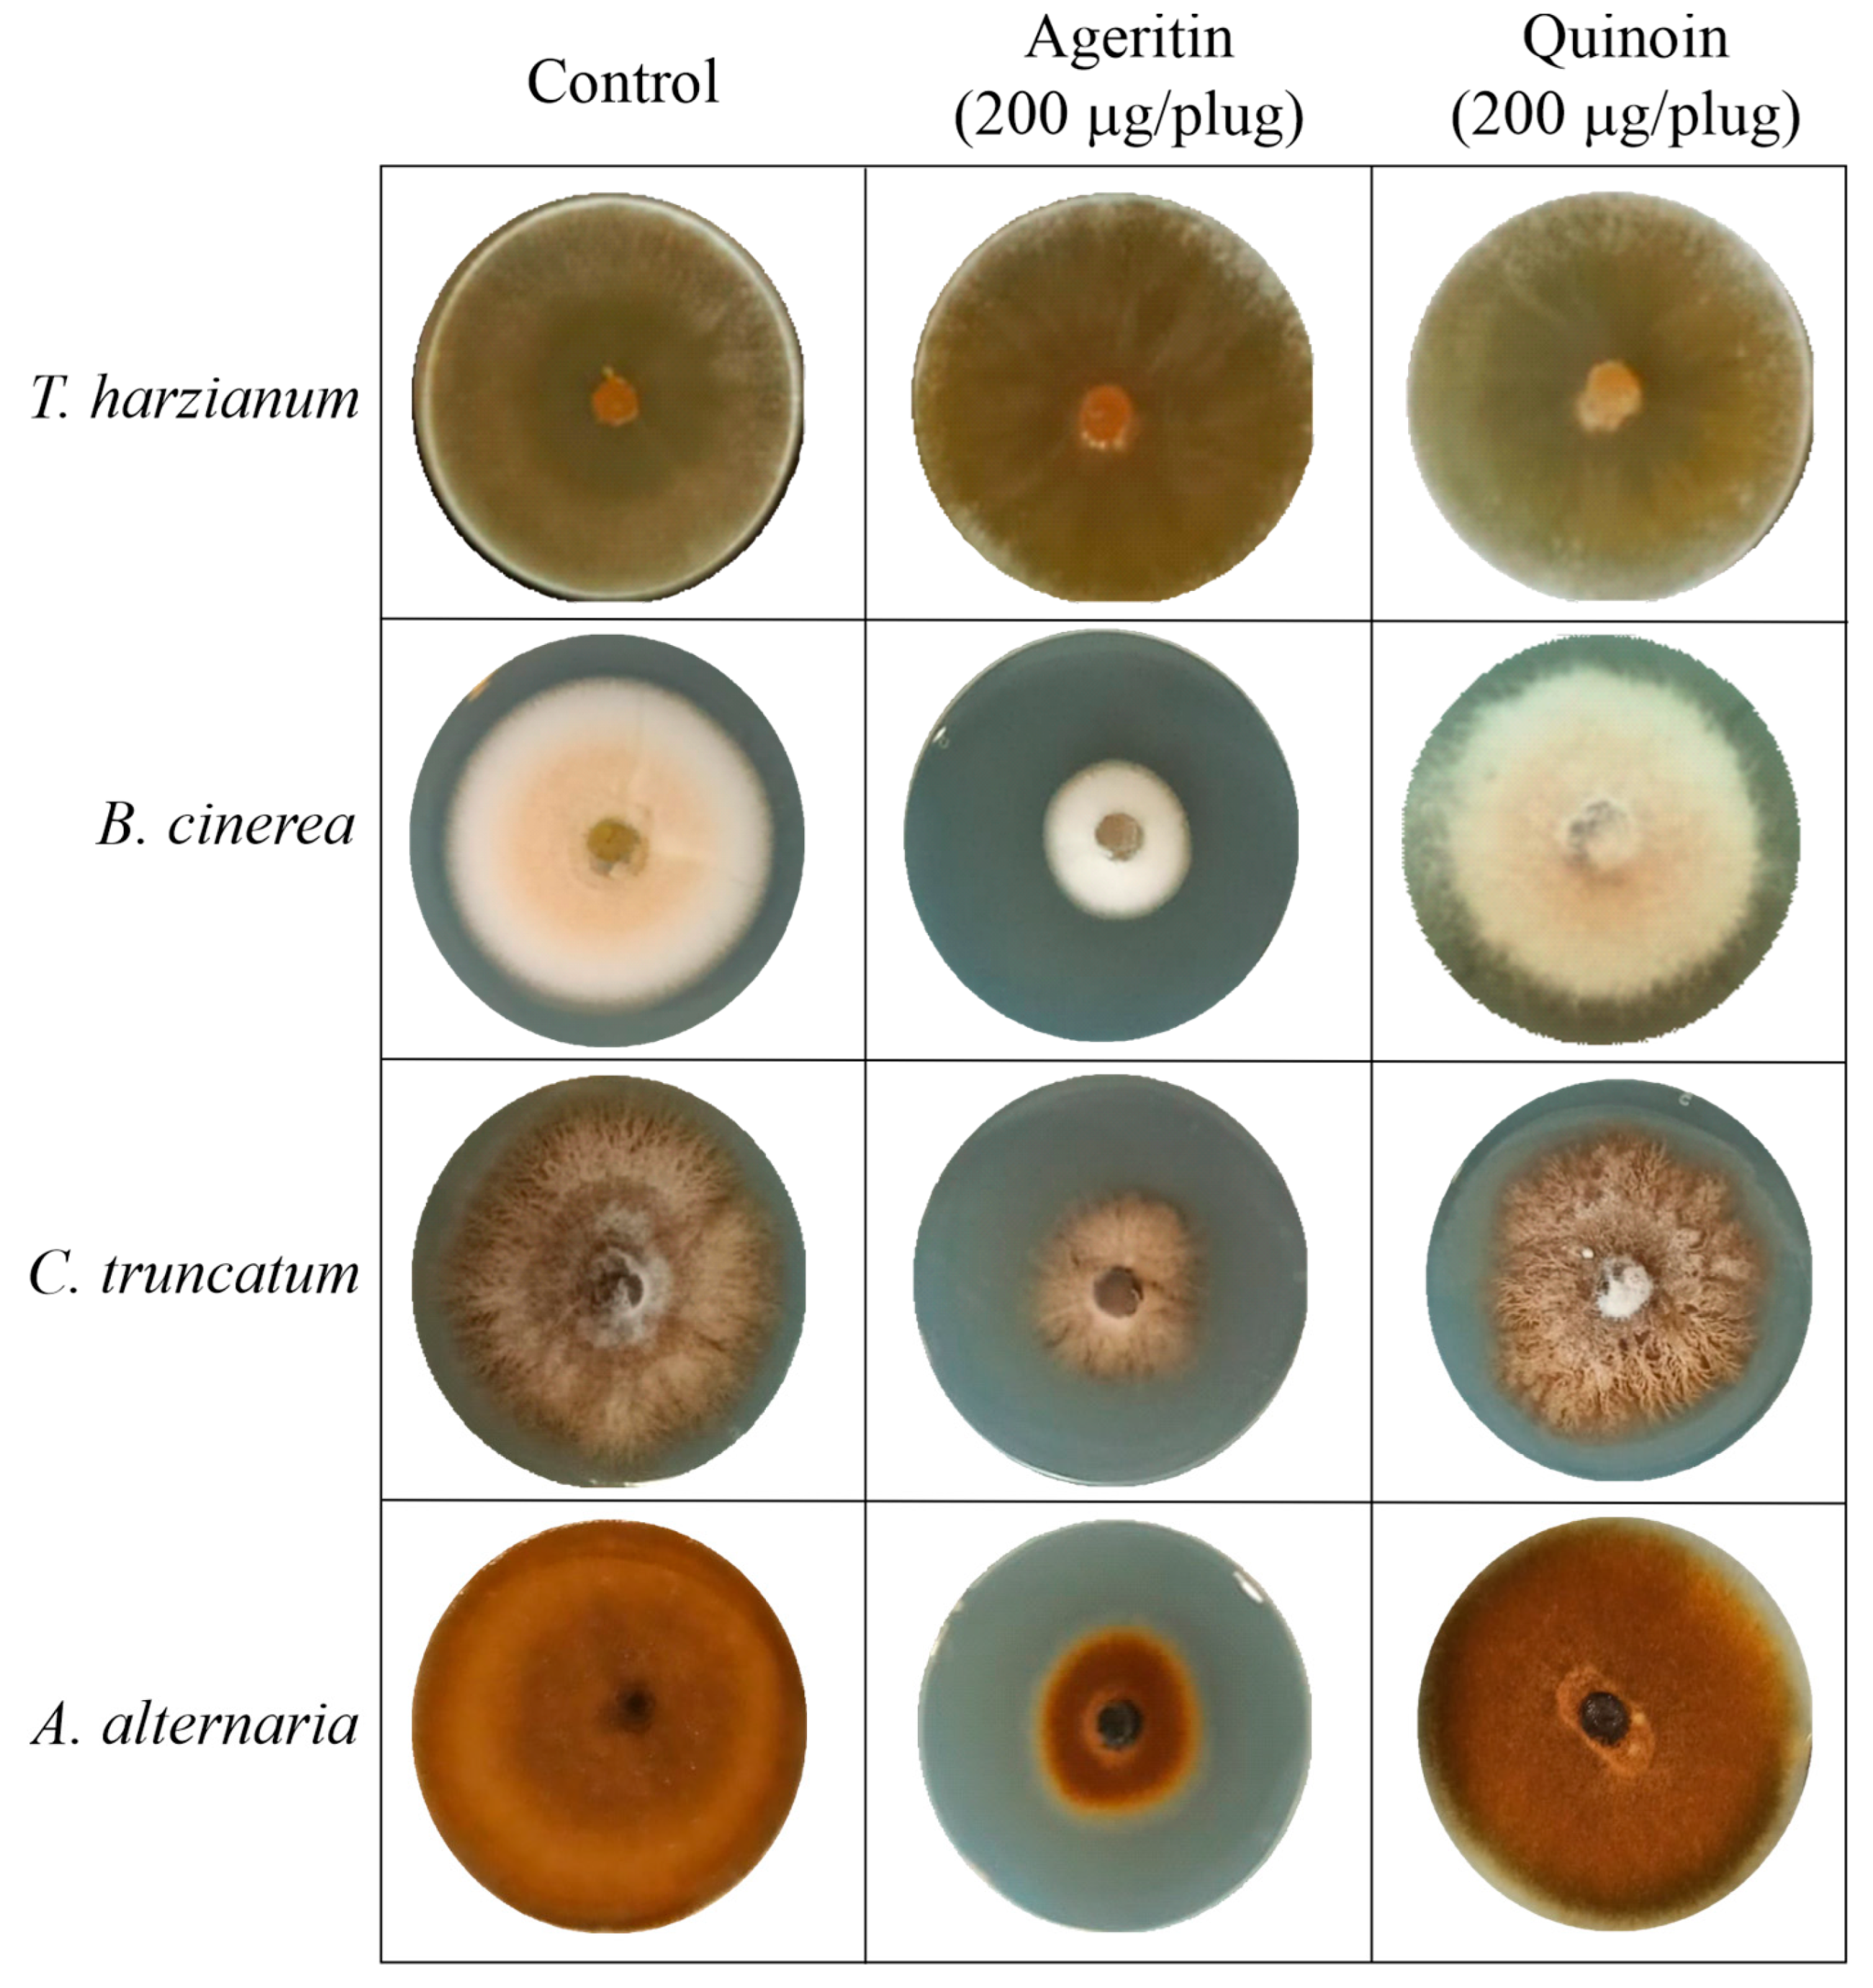
Toxins 15 00578 g002

Antifungal Activity of Ageritin, a Ribotoxin-like Protein from Cyclocybe aegerita Edible Mushroom, against Phytopathogenic Fungi
Abstract
:1. Introduction
2. Results and Discussion
2.1. Ageritin and Quinoin Isolation
2.2. Antifungal Activity of Ageritin and Quinoin in Solid Medium
2.3. Antifungal Activity of Ageritin in the Presence of Chitinolytic Enzyme
2.4. Susceptibility of T. harzianum and B. cinerea Ribosomes to Ageritin and Quinoin
2.5. Antifungal Activity of Ageritin and Quinoin in Liquid Medium
3. Conclusions
4. Materials and Methods
4.1. Materials
4.2. Ageritin and Quinoin Purification
4.3. Biochemical Analytical Procedures
4.4. Fungal Cultures
4.5. Antifungal Activity Detection of Ageritin and Quinoin
4.6. Production of Conidia
4.7. Preparation of T. harzianum and B. cinerea S30
4.8. rRNA Ribonucleolytic Activity on T. harzianum and B. cinerea Ribosomes
4.9. Antifungal Activity in Liquid Medium
4.10. Ribosome Inactivation Analysis in T. harzianum and B. cinerea Cultures
4.11. Statistical Analysis
Supplementary Materials
Author Contributions
Funding
Institutional Review Board Statement
Informed Consent Statement
Data Availability Statement
Acknowledgments
Conflicts of Interest
Abbreviations
References
- Ragucci, S.; Landi, N.; Russo, R.; Valletta, M.; Pedone, P.V.; Chambery, A.; Di Maro, A. Ageritin from Pioppino Mushroom: The Prototype of Ribotoxin-Like Proteins, a Novel Family of Specific Ribonucleases in Edible Mushrooms. Toxins 2021, 13, 263. [Google Scholar] [CrossRef] [PubMed]
- Szewczak, A.A.; Moore, P.B. The Sarcin/Ricin Loop, a Modular RNA. J. Mol. Biol. 1995, 247, 81–98. [Google Scholar] [CrossRef] [PubMed]
- Olombrada, M.; Lázaro-Gorines, R.; López-Rodríguez, J.C.; Martínez-Del-Pozo, Á.; Oñaderra, M.; Maestro-López, M.; Lacadena, J.; Gavilanes, J.G.; García-Ortega, L. Fungal Ribotoxins: A Review of Potential Biotechnological Applications. Toxins 2017, 9, 71. [Google Scholar] [CrossRef] [PubMed]
- Olombrada, M.; Martínez-del-Pozo, A.; Medina, P.; Budia, F.; Gavilanes, J.G.; García-Ortega, L. Fungal ribotoxins: Natural protein-based weapons against insects. Toxicon 2014, 83, 69–74. [Google Scholar] [CrossRef] [PubMed]
- Lampitella, E.; Landi, N.; Oliva, R.; Ragucci, S.; Petraccone, L.; Berisio, R.; Di Maro, A.; Del Vecchio, P. Conformational stability of ageritin, a metal binding ribotoxin-like protein of fungal origin. Int. J. Biol. Macromol. 2022, 221, 1012–1021. [Google Scholar] [CrossRef] [PubMed]
- Ruggiero, A.; García-Ortega, L.; Ragucci, S.; Russo, R.; Landi, N.; Berisio, R.; Di Maro, A. Structural and enzymatic properties of Ageritin, a novel metal-dependent ribotoxin-like protein with antitumor activity. Biochim. Biophys. Acta Gen. Subj. 2018, 1862, 2888–2894. [Google Scholar] [CrossRef] [PubMed]
- Tayyrov, A.; Azevedo, S.; Herzog, R.; Vogt, E.; Arzt, S.; Lüthy, P.; Müller, P.; Rühl, M.; Hennicke, F.; Künzler, M. Heterologous Production and Functional Characterization of Ageritin, a Novel Type of Ribotoxin Highly Expressed during Fruiting of the Edible Mushroom Agrocybe aegerita. Appl. Environ. Microbiol. 2019, 85, e01549-19. [Google Scholar] [CrossRef] [PubMed]
- Xiao, Z.; Zhao, Q.; Li, W.; Gao, L.; Liu, G. Strain improvement of Trichoderma harzianum for enhanced biocontrol capacity: Strategies and prospects. Front. Microbiol. 2023, 14, 1146210. [Google Scholar] [CrossRef]
- Kanjanamaneesathian, M. Biological Control of Diseases of Vegetables Grown Hydroponically in Thailand: Challenge and Opportunity. Recent Pat. Biotechnol. 2015, 9, 214–222. [Google Scholar] [CrossRef]
- Ragucci, S.; Bulgari, D.; Landi, N.; Russo, R.; Clemente, A.; Valletta, M.; Chambery, A.; Gobbi, E.; Faoro, F.; Di Maro, A. The Structural Characterization and Antipathogenic Activities of Quinoin, a Type 1 Ribosome-Inactivating Protein from Quinoa Seeds. Int. J. Mol. Sci. 2021, 22, 8964. [Google Scholar] [CrossRef]
- Endo, Y.; Tsurugi, K. The RNA N-glycosidase activity of ricin A-chain. The characteristics of the enzymatic activity of ricin A-chain with ribosomes and with rRNA. J. Biol. Chem. 1988, 263, 8735–8739. [Google Scholar] [CrossRef] [PubMed]
- Liu, J.; Wen, D.; Song, X.; Su, P.; Lou, J.; Yao, D.; Zhang, C. Evolution and natural selection of ribosome-inactivating proteins in bacteria, fungi, and plants. Int. J. Biol. Macromol. 2023, 248, 125929. [Google Scholar] [CrossRef] [PubMed]
- Dougherty, K.; Hudak, K.A. Phylogeny and domain architecture of plant ribosome inactivating proteins. Phytochemistry 2022, 202, 113337. [Google Scholar] [CrossRef] [PubMed]
- Stirpe, F. Ribosome-inactivating proteins: From toxins to useful proteins. Toxicon 2013, 67, 12–16. [Google Scholar] [CrossRef] [PubMed]
- Sharma, A.; Gupta, S.; Sharma, N.R.; Paul, K. Expanding role of ribosome-inactivating proteins: From toxins to therapeutics. IUBMB Life 2023, 75, 82–96. [Google Scholar] [CrossRef] [PubMed]
- Kocyigit, E.; Kocaadam-Bozkurt, B.; Bozkurt, O.; Ağagündüz, D.; Capasso, R. Plant Toxic Proteins: Their Biological Activities, Mechanism of Action and Removal Strategies. Toxins 2023, 15, 356. [Google Scholar] [CrossRef] [PubMed]
- De Zaeytijd, J.; Van Damme, E.J. Extensive Evolution of Cereal Ribosome-Inactivating Proteins Translates into Unique Structural Features, Activation Mechanisms, and Physiological Roles. Toxins 2017, 9, 123. [Google Scholar] [CrossRef] [PubMed]
- Akkouh, O.; Ng, T.B.; Cheung, R.C.; Wong, J.H.; Pan, W.; Ng, C.C.; Sha, O.; Shaw, P.C.; Chan, W.Y. Biological activities of ribosome-inactivating proteins and their possible applications as antimicrobial, anticancer, and anti-pest agents and in neuroscience research. Appl. Microbiol. Biotechnol. 2015, 99, 9847–9863. [Google Scholar] [CrossRef]
- Zhu, F.; Zhou, Y.K.; Ji, Z.L.; Chen, X.R. The Plant Ribosome-Inactivating Proteins Play Important Roles in Defense against Pathogens and Insect Pest Attacks. Front. Plant Sci. 2018, 9, 146. [Google Scholar] [CrossRef]
- Citores, L.; Iglesias, R.; Ferreras, J.M. Antiviral Activity of Ribosome-Inactivating Proteins. Toxins 2021, 13, 80. [Google Scholar] [CrossRef]
- Castaldi, S.; Zorrilla, J.G.; Petrillo, C.; Russo, M.T.; Ambrosino, P.; Masi, M.; Cimmino, A.; Isticato, R. Alternaria alternata Isolated from Infected Pears (Pyrus communis) in Italy Produces Non-Host Toxins and Hydrolytic Enzymes as Infection Mechanisms and Exhibits Competitive Exclusion against Botrytis cinerea in Co-Infected Host Fruits. J. Fungi 2023, 9, 326. [Google Scholar] [CrossRef] [PubMed]
- Cheung, N.; Tian, L.; Liu, X.; Li, X. The Destructive Fungal Pathogen Botrytis cinerea-Insights from Genes Studied with Mutant Analysis. Pathogens 2020, 9, 923. [Google Scholar] [CrossRef] [PubMed]
- Masi, M.; Castaldi, S.; Sautua, F.; Pescitelli, G.; Carmona, M.A.; Evidente, A. Truncatenolide, a Bioactive Disubstituted Nonenolide Produced by Colletotrichum truncatum, the Causal Agent of Anthracnose of Soybean in Argentina: Fungal Antagonism and SAR Studies. J. Agric. Food Chem. 2022, 70, 9834–9844. [Google Scholar] [CrossRef] [PubMed]
- Downie, R.C.; Lin, M.; Corsi, B.; Ficke, A.; Lillemo, M.; Oliver, R.P.; Phan, H.T.T.; Tan, K.C.; Cockram, J. Septoria Nodorum Blotch of Wheat: Disease Management and Resistance Breeding in the Face of Shifting Disease Dynamics and a Changing Environment. Phytopathology 2021, 111, 906–920. [Google Scholar] [CrossRef] [PubMed]
- Patil, R.S.; Ghormade, V.; Deshpande, M.V. Chitinolytic enzymes: An exploration. Enzyme Microb. Technol. 2000, 26, 473–483. [Google Scholar] [CrossRef] [PubMed]
- Taira, T.; Ohnuma, T.; Yamagami, T.; Aso, Y.; Ishiguro, M.; Ishihara, M. Antifungal activity of rye (Secale cereale) seed chitinases: The different binding manner of class I and class II chitinases to the fungal cell walls. Biosci. Biotechnol. Biochem. 2002, 66, 970–977. [Google Scholar] [CrossRef] [PubMed]
- Zawada, J.F. Preparation and testing of E. coli S30 in vitro transcription translation extracts. Methods Mol. Biol. 2012, 805, 31–41. [Google Scholar] [CrossRef]
- Ehren, H.L.; Appels, F.V.W.; Houben, K.; Renault, M.A.M.; Wösten, H.A.B.; Baldus, M. Characterization of the cell wall of a mushroom forming fungus at atomic resolution using solid-state NMR spectroscopy. Cell Surf. 2020, 6, 100046. [Google Scholar] [CrossRef]
- Fernando, L.D.; Dickwella Widanage, M.C.; Shekar, S.C.; Mentink-Vigier, F.; Wang, P.; Wi, S.; Wang, T. Solid-state NMR analysis of unlabeled fungal cell walls from Aspergillus and Candida species. J. Struct. Biol. X 2022, 6, 100070. [Google Scholar] [CrossRef]
- Veiter, L.; Rajamanickam, V.; Herwig, C. The filamentous fungal pellet-relationship between morphology and productivity. Appl. Microbiol. Biotechnol. 2018, 102, 2997–3006. [Google Scholar] [CrossRef]
- Latgé, J.P. Tasting the fungal cell wall. Cell Microbiol. 2010, 12, 863–872. [Google Scholar] [CrossRef] [PubMed]
- Berkow, E.L.; Lockhart, S.R.; Ostrosky-Zeichner, L. Antifungal Susceptibility Testing: Current Approaches. Clin. Microbiol. Rev. 2020, 33, e00069-00019. [Google Scholar] [CrossRef] [PubMed]
- Laemmli, U.K. Cleavage of structural proteins during the assembly of the head of bacteriophage T4. Nature 1970, 227, 680–685. [Google Scholar] [CrossRef] [PubMed]
- Walker, J.M. The bicinchoninic acid (BCA) assay for protein quantitation. Methods Mol. Biol. 1994, 32, 5–8. [Google Scholar] [CrossRef] [PubMed]
- Rodriguez-Nogales, J.M.; Garcia, M.C.; Marina, M.L. High-performance liquid chromatography and capillary electrophoresis for the analysis of maize proteins. J. Sep. Sci. 2006, 29, 197–210. [Google Scholar] [CrossRef] [PubMed]
- Citores, L.; Iglesias, R.; Gay, C.; Ferreras, J.M. Antifungal activity of the ribosome-inactivating protein BE27 from sugar beet (Beta vulgaris L.) against the green mould Penicillium digitatum. Mol. Plant Pathol. 2016, 17, 261–271. [Google Scholar] [CrossRef]
- Iglesias, R.; Citores, L.; Ferreras, J.M. Ribosomal RNA N-glycosylase Activity Assay of Ribosome-inactivating Proteins. Bio Protoc. 2017, 7, e2180. [Google Scholar] [CrossRef]

Disclaimer/Publisher’s Note: The statements, opinions and data contained in all publications are solely those of the individual author(s) and contributor(s) and not of MDPI and/or the editor(s). MDPI and/or the editor(s) disclaim responsibility for any injury to people or property resulting from any ideas, methods, instructions or products referred to in the content. |
© 2023 by the authors. Licensee MDPI, Basel, Switzerland. This article is an open access article distributed under the terms and conditions of the Creative Commons Attribution (CC BY) license (https://creativecommons.org/licenses/by/4.0/).
Share and Cite
Ragucci, S.; Castaldi, S.; Landi, N.; Isticato, R.; Di Maro, A. Antifungal Activity of Ageritin, a Ribotoxin-like Protein from Cyclocybe aegerita Edible Mushroom, against Phytopathogenic Fungi. Toxins 2023, 15, 578. https://doi.org/10.3390/toxins15090578
Ragucci S, Castaldi S, Landi N, Isticato R, Di Maro A. Antifungal Activity of Ageritin, a Ribotoxin-like Protein from Cyclocybe aegerita Edible Mushroom, against Phytopathogenic Fungi. Toxins. 2023; 15(9):578. https://doi.org/10.3390/toxins15090578
Chicago/Turabian StyleRagucci, Sara, Stefany Castaldi, Nicola Landi, Rachele Isticato, and Antimo Di Maro. 2023. "Antifungal Activity of Ageritin, a Ribotoxin-like Protein from Cyclocybe aegerita Edible Mushroom, against Phytopathogenic Fungi" Toxins 15, no. 9: 578. https://doi.org/10.3390/toxins15090578
APA StyleRagucci, S., Castaldi, S., Landi, N., Isticato, R., & Di Maro, A. (2023). Antifungal Activity of Ageritin, a Ribotoxin-like Protein from Cyclocybe aegerita Edible Mushroom, against Phytopathogenic Fungi. Toxins, 15(9), 578. https://doi.org/10.3390/toxins15090578

